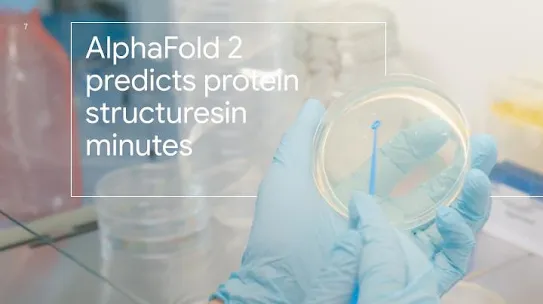

Tonton video
Memajukan Malaysia Bersama
Memperkukuh ekosistem digital ke arah masyarakat yang saksama dan inklusif.
Memacu pertumbuhan ekonomi dengan AI

Tonton video
Link to Youtube Video (visible only when JS is disabled)
Membina AI untuk memberi manfaat sosial
-
AlphaFold mempunyai potensi untuk mempercepatkan penyelidikan bioperubatan dan pembangunan ubat
AlphaFold Google DeepMind membolehkan berjuta-juta ahli sains memajukan lagi pemahaman biologi serta membantu penyakit-penyakit yang masih belum boleh dirawat.
-
Membantu kanak-kanak membaca Bahasa Inggeris dengan AI
Dengan bantuan AI, apl Read Along memberikan bantuan masa nyata dan sokongan sebutan kepada kanak-kanak.
-
Membantu rakyat Malaysia mempelajari cara menggunakan alat Gen AI
Google AI Essentials membolehkan rakyat Malaysia mempelajari cara menggunakan Gen AI bagi mempercepatkan urusan harian.
Impak Google di Malaysia
-
RM15 bilion
dijana dalam aktiviti ekonomi untuk perniagaan daripada alatan seperti Google Search, Ads, Play, Cloud dan YouTube.
-
52,000 pekerjaan
disokong oleh produk dan perkhidmatan Google pada tahun 2023, dengan tambahan 59,900 pekerjaan yang dijana melalui ekosistem apl Android.
-
>355,000
rakyat Malaysia dilatih dalam kemahiran digital melalui inisiatif Grow with Google.